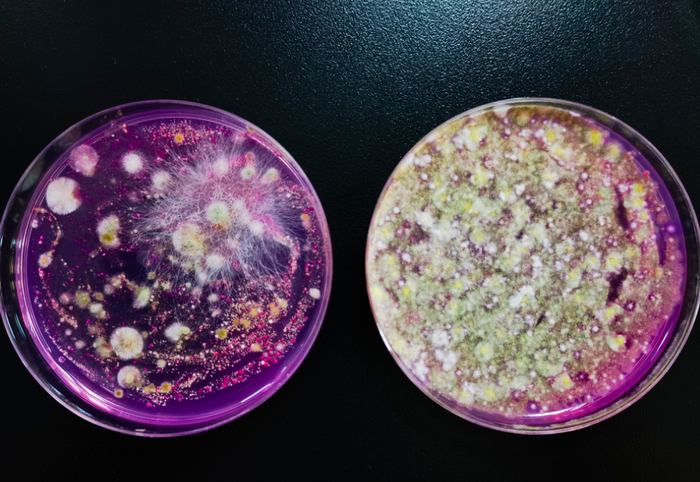
▲图源：丁香医生

转自:深圳卫健委
暑假在家时你妈:
“冷气一日到黑开咁猛,唔惊吹出病?
你唔唞(休息)空调都要唞架”


▲图源:小红书用户@张鸭鸭
不过,咱妈这话没说错
空调不清理还经常吹
真可能把人“吹病”

高温天吹空调
防脏是头等大事
一不留神
你的空调就悄悄变成
“吸尘器”
👇

▲图源:丁香医生
01
空调有多脏?
假如你家的空调,已经使用了很多年,但却从未清洗的话,那么现在你打开空调盖,找到它的滤网——
它可能是长这个样子的

▲图源:小红书用户@闹闹捏果
用手一摸,厚厚的一层灰,长时间吹这样的空调,真的不卫生。
如果年头再久一点,那么不仅仅是滤网,就连出风口上可能也都会是灰尘。

▲图源:丁香医生
这些脏东西不仅仅由灰尘构成,里面还混杂着螨虫,以及细菌、病毒等微生物!
这是因为空调在使用一段时间后,空气中的微小粉尘和微生物都会穿过过滤网,进入空调内部,与散热片上的冷凝水粘合并聚集在散热片上。
不仅如此,空调内部潮湿的环境,也为这些微生物提供了很好的繁衍条件。
▲图源:丁香医生
此前,中国环境科学学会室内环境与健康分会对北京、深圳两座城市的家用空调做了入户调研,调研后发现:
88%的空调,其散热片细菌总数是超标的,并且每平方厘米上的细菌含量达到了 288~1200 CFU(CFU,菌落形成单位,《公共场所集中空调系统清洗消毒规范》规定,清洗消毒后的空调部件细菌总数应小于 100 CFU/c㎡。)
湖南卫视的《新闻大求真》节目,节目组在空调散热片上还检出了金黄色葡萄球菌、军团菌等致病菌。

▲图源:《空调系统微生物种类分析及其温湿度控制》
看到这里,你是不是已经对你的空调感到了一丝丝恐惧,想立刻关机清理?
接下来,我们就来说说该如何清洗空调。
02
自己如何清洗空调?
根据中国家用电器商业协会 2017 年发布的《智能自清洁空调行业白皮书》来看:
有超过30%的用户从不清洗空调。


疾病专家提醒:
家用分体空调使用中也会变脏,必要时应该进行清洗,防止空调内积攒的一些螨虫、霉菌及其它病原微生物引起过敏、感染。
所以,在每年夏天使用空调前,一定要记住:使用前务必要先清洗干净!


▲图源:《新闻大求真》节目
当然,现在清洗也来得及。
你可以选择自己动手,也可以请专业师傅上门,主要看你家用的是哪一种空调。
空调一共有三个部位需要清洗,它们分别是:出风口、过滤网和翅片(也就是前面说到的散热片)。
出风口露在外面,它的清洗非常简单,拿上一块软布蘸上清洁剂,轻轻擦拭干净就可以了,擦不到的地方,就换一个软毛牙刷伸进去擦拭。
过滤网和翅片都装在空调的内部,要擦拭它们,则需要拆空调。
1
壁挂式空调清洗
第一步
戴好口罩,空调断电
向上打开空调盖,取出过滤网

第二步
拿到流动的干净水下,跟吹风的方向反向冲洗,可以用软刷或软布蘸中性清洁剂擦拭
若过滤网积灰严重,可以放在含有中性清洁剂的水中浸泡10~15分钟
过滤网洗净后,晾干

第三步
使用空调专用泡沫清洁剂,喷在翅片上,静置10~15分钟

第四步
将过滤网装回空调,向下合上空调盖
插上电源,启动空调制冷模式,翅片上的污水会随着排水管自动排出

需要注意的是,翅片相对较脆弱,过度用力擦拭可能会导致翅片变形,因此不建议用抹布擦拭,可以选择购买“翅片刷”,将翅片上的灰尘扫下。
2
立柜式空调
立柜式空调的清洗步骤和壁挂式空调是一样的。
它俩的区别在于:取出过滤网的方式不一样,还有翅片的位置不一样。
立柜式空调,虽然分为好几种款式,但每种款式,都需要用螺丝刀扭开机身面盖两边的螺丝,才能打开空调盖子,取出过滤网。

▲图源:网络
不同款式的立柜式空调,翅片安装的位置不一样,其中:
- 格栅式空调的翅片在出风口挡板附近;
滑盖式空调需要先启动电源,待滑盖滑下、正常出风后再断电,从空调出风口挡板往里看,找到翅片的位置。
03
多久清洗一次最合适?
在空调使用的过程中,要观察过滤网上的灰尘积聚情况,及时清洗,避免灰尘堵塞过滤网,影响制冷效果和空气卫生。
即使你想图省事,过滤网每年也要做到至少清洗2-3次,也就是说:
每年空调第一次开机前清洗一次
上一年空调季结束时清洗了过滤网,这一遍可不用洗;空调季节过半后再清洗一次;
空调季节结束时再清洗一次。




